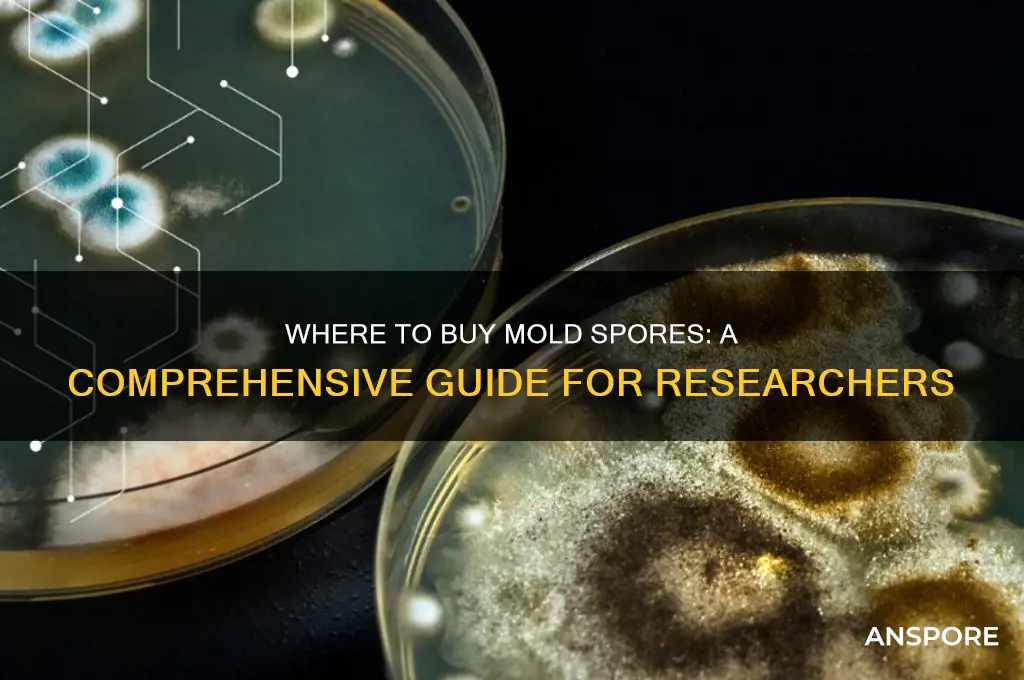
can you buy mold spores

The question of whether you can buy mold spores is a topic that intersects with scientific research, industrial applications, and even artistic endeavors. Mold spores, the microscopic reproductive units of fungi, are naturally present in the environment and play a crucial role in ecosystems. However, for specific purposes such as laboratory studies, mycology, or creating spore prints for art, individuals and organizations may seek to purchase mold spores. Commercially available spores are typically sold by specialized suppliers, often in controlled quantities and strains, to ensure safety and compliance with regulations. While some spores are readily accessible for legitimate uses, others may be restricted due to potential health risks or environmental concerns. Understanding the availability, legality, and ethical considerations surrounding the purchase of mold spores is essential for anyone interested in this niche yet fascinating subject.
| Characteristics | Values |
|---|---|
| Availability | Yes, mold spores can be purchased from various online suppliers and laboratories. |
| Purpose | Primarily for scientific research, education, and industrial applications (e.g., mycology studies, enzyme production, or bioremediation). |
| Types Available | Common species include Aspergillus, Penicillium, Trichoderma, and Fusarium. |
| Form | Spores are typically sold as spore suspensions, agar plates, or slants. |
| Legality | Legal to purchase for legitimate purposes, but regulations vary by country and species. |
| Safety Concerns | Handling requires proper safety equipment (e.g., lab coats, gloves, and fume hoods) to avoid health risks. |
| Storage | Spores are often stored in refrigerated conditions to maintain viability. |
| Cost | Prices vary depending on species, quantity, and supplier, typically ranging from $20 to $200 per unit. |
| Suppliers | Examples include Carolina Biological Supply, ATCC (American Type Culture Collection), and specialized mycology suppliers. |
| Shipping | Often shipped with cold packs or dry ice to ensure viability during transit. |
| Ethical Use | Buyers are expected to adhere to ethical guidelines and avoid misuse (e.g., bioterrorism or illegal activities). |
Explore related products
What You'll Learn
- Sources of Mold Spores: Where to find and purchase mold spores legally and safely
- Types of Mold Spores: Different species available for purchase, such as Penicillium or Aspergillus
- Legal Considerations: Regulations and restrictions on buying and owning mold spores in various regions
- Uses of Mold Spores: Applications in research, education, food production, and remediation projects
- Safety Precautions: Guidelines for handling purchased mold spores to prevent contamination or health risks

Sources of Mold Spores: Where to find and purchase mold spores legally and safely
Mold spores are ubiquitous in nature, but for those seeking to purchase them legally and safely, specific sources cater to various needs, from scientific research to food production. One primary avenue is specialized laboratories and scientific suppliers, which offer a range of mold spore cultures for academic, industrial, or medical purposes. Companies like ATCC (American Type Culture Collection) and Carolina Biological Supply provide authenticated strains of molds such as *Aspergillus* or *Penicillium*, often used in microbiology studies or pharmaceutical development. These suppliers ensure spores are sterile, viable, and compliant with regulatory standards, making them ideal for controlled environments.
For culinary enthusiasts, gourmet food suppliers are a surprising yet legitimate source of mold spores. Cheese-making kits, for instance, often include *Penicillium camemberti* or *Penicillium roqueforti* spores to cultivate Camembert or blue cheese at home. Websites like New England Cheesemaking Supply or The Cheesemaker offer these spores in pre-measured packets, complete with instructions for safe handling and optimal fermentation conditions. While these spores are food-safe, users should follow dosage guidelines—typically 1-2 grams of spore solution per 2 gallons of milk—to avoid contamination or uneven results.
Another niche market is mycology and mushroom cultivation, where mold spores like *Trichoderma* are used to promote healthy fungal growth or combat pests. Suppliers such as Fungi Perfecti or SporeStore provide spores in spore syringes or spore prints, often accompanied by detailed guides for sterile techniques. These products are legal but require caution: improper handling can lead to unintended mold growth in living spaces. Always use a laminar flow hood or still air box when working with spores to maintain sterility.
Lastly, DIY and hobbyist platforms like Etsy or eBay occasionally list mold spores, but buyers must exercise caution. While some sellers offer legitimate products for art projects (e.g., *Aspergillus* for biopigments), others may lack proper documentation or safety standards. Verify the seller’s credentials, request certificates of analysis, and ensure the spores are intended for legal, non-harmful uses. For instance, *Aspergillus oryzae* spores, used in fermentation, are safe for culinary applications but should never be inhaled or mishandled.
In summary, purchasing mold spores legally and safely hinges on selecting reputable sources aligned with your purpose. Whether for science, food, or hobby, prioritize suppliers that provide documentation, handling instructions, and compliance with regulations. Always wear protective gear, such as gloves and masks, when working with spores to minimize health risks. With the right precautions, mold spores can be a valuable resource rather than a hazard.
Exploring the Potential for Spore Mines to Advance in Modern Warfare
You may want to see also

Types of Mold Spores: Different species available for purchase, such as Penicillium or Aspergillus
Mold spores, the microscopic seeds of fungi, are not only available for purchase but also come in a variety of species, each with unique characteristics and applications. For instance, Penicillium is widely recognized for its role in producing antibiotics like penicillin, while Aspergillus is prized in the food industry for fermenting products such as soy sauce and cheese. These spores are sold by specialized suppliers, often targeting researchers, educators, and hobbyists who require them for experiments, educational demonstrations, or fermentation projects. Understanding the specific traits of each species is crucial, as their uses—and potential risks—vary significantly.
When purchasing mold spores, it’s essential to consider the intended application. Penicillium species, for example, are commonly used in microbiology labs to study antibiotic production or in DIY projects like making blue cheese. Suppliers often provide spores in vials or plates, with instructions for cultivation. Dosage and handling are critical; even a small amount of Penicillium spores can colonize a substrate rapidly, so precision is key. Conversely, Aspergillus spores are frequently used in food fermentation, where controlled growth is necessary to avoid over-fermentation or contamination. Always follow supplier guidelines, especially when working with species like *Aspergillus niger*, which can produce toxic compounds if mishandled.
From a comparative perspective, Penicillium and Aspergillus differ not only in their applications but also in their growth requirements. Penicillium thrives in cooler, moist environments, making it ideal for cheese aging or laboratory settings. Aspergillus, however, prefers warmer conditions and is more versatile in its substrate preferences, from grains to fruits. This distinction influences how spores are stored and cultivated. For instance, Penicillium spores may require refrigeration, while Aspergillus spores can often be kept at room temperature. Understanding these nuances ensures successful cultivation and minimizes the risk of unintended mold growth.
For practical use, always source spores from reputable suppliers who provide detailed product information, including species identification and handling instructions. Beginners should start with user-friendly species like *Penicillium camemberti* for cheese making or *Aspergillus oryzae* for fermenting rice. Avoid purchasing spores without a clear purpose, as improper use can lead to health risks or environmental contamination. Additionally, ensure proper ventilation and use personal protective equipment, such as gloves and masks, when handling spores to prevent inhalation or skin contact. With the right precautions, exploring the world of mold spores can be both educational and rewarding.
Exploring Galactic Adventures: Can You Purchase It Without Spore?
You may want to see also

Legal Considerations: Regulations and restrictions on buying and owning mold spores in various regions
The legality of purchasing and owning mold spores varies significantly across regions, influenced by their potential use in scientific research, agriculture, or illicit activities like drug production. In the United States, for instance, mold spores themselves are not regulated under federal law, but their application determines legality. Spores of *Aspergillus* or *Penicillium* species, commonly used in academic or industrial settings, are freely available from suppliers like Carolina Biological Supply or ATCC. However, spores of *Psilocybian* mushrooms, which contain psychoactive compounds, fall under controlled substance regulations, making their possession illegal in most states unless for licensed research.
In contrast, the European Union takes a more cautious approach, categorizing certain mold spores under the Biocidal Products Regulation (BPR) if they are used for biocidal purposes. For example, spores of *Trichoderma* species, often used in biocontrol, must comply with strict safety and efficacy assessments before sale. Additionally, countries like Germany and the Netherlands have specific national laws restricting the sale of spores linked to psychoactive substances, even for personal use. These regulations reflect a broader concern about misuse and public health risks.
In Asia, the legal landscape is fragmented and often stricter. China, for instance, classifies mold spores used in fermentation processes (e.g., *Aspergillus oryzae* for soy sauce production) as food-grade materials, subject to health and safety standards. However, spores associated with psychoactive fungi are banned outright, with severe penalties for possession or distribution. Similarly, Japan permits the sale of mold spores for traditional fermentation practices but prohibits those linked to controlled substances, aligning with its strict drug enforcement policies.
For individuals or organizations considering purchasing mold spores, due diligence is essential. First, identify the intended use and verify local regulations. For research or industrial purposes, ensure the supplier provides documentation confirming compliance with regional laws. Second, avoid purchasing spores from unverified sources, especially online marketplaces, as these may lack proper labeling or contain prohibited strains. Finally, stay informed about evolving regulations, as changes in legislation can impact legality and penalties.
In summary, while mold spores are widely available for legitimate purposes, their legal status hinges on regional regulations and intended use. Navigating this complex landscape requires careful research, adherence to local laws, and reliance on reputable suppliers. Whether for scientific research, agriculture, or industrial applications, understanding these legal considerations is crucial to avoiding unintended consequences.
Mold Spores & Mites: Unseen Forces Behind Mysterious Movements?
You may want to see also
Explore related products
$13.48 $14.13

Uses of Mold Spores: Applications in research, education, food production, and remediation projects
Mold spores, often viewed as nuisances, are commercially available and serve diverse purposes across industries. For researchers, purchasing specific mold strains like *Aspergillus niger* or *Penicillium chrysogenum* enables controlled studies on mycotoxin production, biodegradation, or antibiotic synthesis. These spores are typically sold in vials or plates, with concentrations ranging from 1,000 to 10,000 colony-forming units (CFUs) per milliliter, ensuring reproducibility in experiments. Laboratories must adhere to biosafety protocols, including HEPA filtration and sterile techniques, to prevent contamination.
In education, mold spores are invaluable for teaching microbiology and environmental science. Kits containing *Rhizopus stolonifer* (black bread mold) or *Neurospora crassa* allow students to observe fungal growth, sporulation, and genetic traits. For instance, *Neurospora* is a classic model for studying circadian rhythms, with experiments requiring agar plates, controlled light cycles, and microscopic analysis. Educators should emphasize safety, such as using gloves and avoiding spore inhalation, especially for younger age groups (12–18 years).
Food production relies on mold spores for fermentation and flavor development. *Penicillium camemberti* and *Penicillium roqueforti* are essential for cheeses like Camembert and Roquefort, respectively. Producers purchase spore suspensions at concentrations of 10^6 CFU/mL, applying them to cheese surfaces during production. Precision in dosage and humidity control (e.g., 90–95% RH for Camembert) ensures consistent quality. Regulatory compliance, such as FDA guidelines for microbial limits, is critical to avoid health risks.
In remediation projects, mold spores are both targets and tools. Bioremediation uses fungi like *Trichoderma* to degrade pollutants, with spores applied at rates of 10^8 CFU/g of contaminated soil. Conversely, monitoring airborne spore counts (e.g., using spore traps) helps assess indoor air quality post-remediation. For example, a post-flood cleanup might aim to reduce *Stachybotrys chartarum* (toxic black mold) levels below 1,000 spores/m³. Professionals must balance spore application for remediation with stringent containment measures to prevent unintended spread.
Across these applications, the availability of mold spores underscores their dual role as both problem and solution. Whether advancing scientific knowledge, educating the next generation, crafting artisanal foods, or restoring environments, the strategic use of mold spores demands precision, safety, and innovation. As industries evolve, so too will the methods for harnessing these microscopic powerhouses.
Are Psilocybe Spores Legal in Minnesota? Understanding Current Laws
You may want to see also

Safety Precautions: Guidelines for handling purchased mold spores to prevent contamination or health risks
Purchased mold spores, often used in research, education, or controlled experiments, require meticulous handling to prevent unintended contamination or health risks. These microscopic organisms, while invaluable in certain contexts, can proliferate rapidly under favorable conditions, posing hazards to both the handler and the environment. Understanding the potential risks and implementing stringent safety measures is essential for anyone working with these materials.
Containment is Key: The first line of defense against mold spore contamination is a robust containment strategy. Always handle purchased spores in a designated biosafety cabinet or laminar flow hood to prevent airborne dispersal. These devices create a sterile environment by filtering the air and directing it away from the user, minimizing the risk of inhalation or environmental contamination. For smaller-scale operations, a simple DIY containment setup using a clear plastic box with glove ports can suffice, though professional equipment is recommended for higher-risk scenarios.
Personal Protective Equipment (PPE): Wearing appropriate PPE is non-negotiable when handling mold spores. At a minimum, this includes nitrile or latex gloves, a lab coat or disposable gown, and safety goggles. For more hazardous strains or prolonged exposure, consider adding a face mask rated for particulate matter (e.g., N95 or higher) and closed-toe shoes. Ensure all PPE is removed and disposed of properly after use to avoid cross-contamination. For example, removing gloves by peeling them away from the skin and immediately washing hands with antimicrobial soap can significantly reduce the risk of transferring spores to personal belongings or living spaces.
Sterilization Protocols: Effective sterilization is critical to preventing the spread of mold spores. All equipment and surfaces that come into contact with the spores must be thoroughly sterilized before and after use. Autoclaving at 121°C (250°F) for 15–20 minutes is the gold standard for sterilizing reusable tools, while disposable items should be placed in biohazard bags and incinerated. For surfaces, use a 10% bleach solution or 70% isopropyl alcohol, ensuring the area remains wet for at least 10 minutes to guarantee spore inactivation. Regularly audit your sterilization procedures to identify and rectify any gaps in your protocol.
Storage and Disposal: Proper storage and disposal of mold spores are often overlooked but equally important. Store spore samples in sealed, labeled containers at temperatures below 4°C (39°F) to inhibit growth. Clearly mark containers with biohazard symbols and expiration dates to prevent accidental misuse. When disposing of spores, follow local biohazard waste regulations, typically involving autoclaving or chemical treatment before disposal in designated containers. For instance, some jurisdictions require mold waste to be treated with a 1:10 bleach solution for 30 minutes prior to disposal.
Training and Documentation: Comprehensive training and meticulous documentation are the cornerstones of safe mold spore handling. All individuals working with these materials should undergo formal training on safety protocols, PPE usage, and emergency response procedures. Maintain detailed records of each session, including the type and quantity of spores used, handling procedures, and any incidents or deviations from protocol. This documentation not only ensures compliance with safety standards but also provides a valuable reference for troubleshooting and improving practices over time.
By adhering to these guidelines, individuals can safely handle purchased mold spores, minimizing risks to themselves and their surroundings. While the process may seem daunting, the combination of proper containment, PPE, sterilization, storage, and training creates a robust framework for responsible spore management. Whether for research, education, or industrial applications, prioritizing safety ensures that the benefits of working with mold spores are realized without compromising health or environmental integrity.
Can Ellie Breathe Spores? Exploring the Science Behind The Last of Us
You may want to see also
Frequently asked questions
Yes, mold spores can be purchased online from various suppliers, including scientific research companies, educational institutions, and hobbyist stores. They are often sold for research, educational, or remediation purposes.
Mold spores are commonly used in scientific research, educational experiments, and for testing mold remediation products. They can also be used in controlled environments to study mold growth and prevention.
Yes, it is generally legal to buy mold spores for legitimate purposes such as research, education, or industrial applications. However, regulations may vary by location, so it’s important to check local laws before purchasing.

























